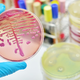
Potencialna protirakava glivična spojina prvič sintetizirana po 55 letih

Pravica do splava ne bi smela biti politično vprašanje, ampak vprašanje javnega zdravstva, poudari teologinja Lana Bobić, in prav nihče ne bi smel vstopati v to intimno odločitev vsake ženske. … · RTV Slovenija · 1M
trenerka fitnesa prekinitev nosečnosti materinska vloga ugovor vesti pravica do splava objavi tvitaj

Ta hitri znak lahko opozarja na resne težave... Obstaja veliko znanih simptomov možganskega tumorja, med katerimi so najpogostejši glavoboli. Vendar pa obstaja eden, ki se pojavi in izgine tako hitro, … · Aktivni.si · 1M

Sprva je delovalo kot nekaj prehodnega, skoraj nedolžnega. Ko je resnica pokazala svoj pravi obraz, se je za to družino začela nočna mora. Kaj nočna mora, čisti pekel! 😱 Holly … · Metropolitan.si · 1M

Nevrologi opozarjajo, da se mnogi od teh znakov pogosto napačno pripisujejo utrujenosti ali staranju. Možgani imajo sposobnost, da vam pošiljajo tihe, a zelo pomembne opozorilne signale, s katerimi lahko pravočasno … · Aktivni.si · 1M

Predstavljajmo si: Torino, 3. januarja 1889. Zunaj je mrzlo. Na Trgu Carla Alberta stoji kočija. Konj, utrujen in trmast, se noče premakniti. Kočijaž izgubi živce. Vzame bič in začne neusmiljeno … · Dnevnik · 1M
antisemitizem filozofija lou andreas-salomé nietzschejeva dela večna vrnitev zgodovina trpljenje duševno zdravje friedrich nietzsche nadčlovek objavi tvitaj
Znanstveniki so po več kot pol stoletja končno uspeli umetno sintetizirati verticilin A, glivično spojino, ki je že dolgo obetala kot potencialno orožje proti raku. Kot navaja ScienceAlert , je … · Vizita.si · 2M
verticilin a kemijska sinteza možganski tumor pri otrocih protirakava spojina onkologija objavi tvitaj

Glioblastom je ena najagresivnejših oblik možganskega raka, ki se razvije iz astrocitov, podpornih celic v možganih in hrbtenjači. Zaradi izjemno hitre rasti in uničevanja zdravega tkiva predstavlja velik izziv tako … · Vizita.si · 2M
glioblastom nevroonkologija zdravljenje glioblastoma možganski tumor astrocitom diagnosticiranje možganskih tumorjev simptomi glioblastoma maligni možganski tumor objavi tvitaj